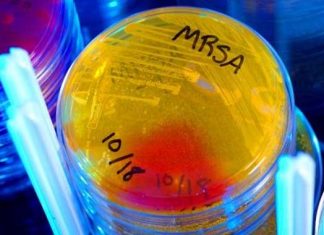
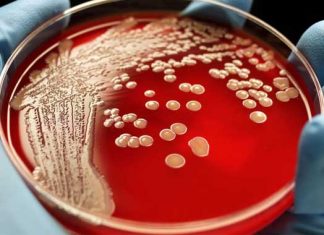

Medicamento experimental prometedor contra las infecciones por SARM mortales
La carrera para encontrar nuevos tratamientos contra el SARM mortal tiene un nuevo competidor en la forma de un fármaco experimental que trata con...
Informática en la predicción de propagación de enfermedades animales
Los científicos han desarrollado un modelo informático que predice brotes de enfermedades zoonóticas - aquellas que se transmiten de animales a las personas -...
Infección por Toxoplasma podría desencadenar enfermedad neurodegenerativa
La infección por el parásito común Toxoplasma gondii - foto de portada -, promueve la acumulación de un neurotransmisor en el cerebro, llamado glutamato,...
El insomnio crónico podría combatirse evitando el tiempo en la cama
Las personas a quienes les resulta difícil conciliar el sueño o permanecer en ello, pueden sorprenderse al saber que una nueva investigación sugiere que...
Epidemia de opioides: 20% de usuarios de analgésicos los comparten
Desde 1999, las muertes por sobredosis de opiáceos - incluyendo los analgésicos de venta por prescripción y la heroína - casi se han cuadruplicado...
La práctica deportiva representa sólo el 18% de las diferencias en...
"La práctica hace la perfección", es una máxima muy conocida y muy contrastable en muchos casos, hasta el punto en el que llegas a...
Actividad cerebral diferenciada entre hombres y mujeres en la cooperación
Todos tenemos una idea, más o menos generalizada, de las diferencias entre hombres y mujeres. Centrémonos en las diferencias sensoriales: los hombres actúan o...
Bebidas gaseosas dietéticas y la diabetes: consideraciones
Según la American Diabetes Association, la diabetes es un grupo de enfermedades caracterizadas por un alto nivel de glucosa en sangre, resultado de defectos...
Banda específica de luz UV mata el SARM sin afectar los...
Las infecciones postquirúrgicas son complicaciones graves y potencialmente mortales. Los métodos actuales de lucha contra las infecciones, especialmente frente a los patógenos resistentes a los...
Precaución a nuevo tratamiento para Esclerosis Múltiple, aunque prometedor
Afinando un tratamiento existente para la esclerosis múltiple (EM) mediante la supresión y luego la reactivación del sistema inmunitario, los resultados se consideran positivos,...
Depresión en niños y adolescentes: mayoría de antidepresivos son ineficaces
Los niños y adolescentes con depresión mayor no se benefician eficazmente de los medicamentos antidepresivos, y algunos de estos medicamentos pueden agravar aún más...
Una prueba de sangre para detectar las primeras etapas de la...
Los investigadores afirman haber desarrollado un análisis de sangre que detecta una etapa temprana de la enfermedad de Alzheimer con "precisión sin igual." La...